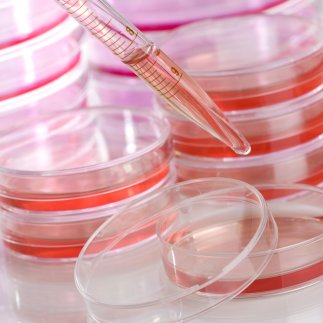

Polystyrol (PS)
Klarheit und Formstabilität für sichtbare Teile

Klar. Steif. Reproduzierbar.
Polystyrol liefert kostengünstige, optisch ansprechende Lösungen für sichtbare Komponenten. Das Portfolio umfasst klare General-Purpose-Typen sowie modifizierte Grades für erhöhte Schlagzähigkeit. Einsatzfreundliche Verarbeitung und attraktive Oberflächen machen PS für Displays und Verpackung attraktiv.
Kernmerkmale auf einem Blick:
- Hervorragende optische Klarheit bei Standardtypen
- Gute Formfüllung und Oberflächenqualität
- Varianten für erhöhte Schlagzähigkeit verfügbar
- Wirtschaftliche Verfügbarkeit für hohe Stückzahlen
Anwendungen
Unsere Produktpalette deckt das gesamte Spektrum von Standardtypen bis zu spezialisierten Hochleistungscompounds ab, die exakt auf Ihre Anforderungen in Lebensmittelverpackungen, Elektronik und Medizin sowie vielen weiteren Branchen abgestimmt sind. Finden Sie Ihr Produktportfolio in dem branchenrelevanten Anwendungssegment.

Eine vielfältige Rohstoffbasis
Unser vielseitiges Produkt-Portfolio an PS-Typen deckt ein breites Anwendungsspektrum ab.
Primärrohstoffe
Polystyrol
Mechanisches Recycling
Post-Consumer (PCR) rPS
Biologisches Recycling
Den richtigen Werkstoff finden. Schritt für Schritt.
Alles Nötige, um aus Konzept Realität werden zu lassen.
Unsere Vision: Geschlossene Materialkreisläufe als Industriestandard.
Unsere Mission: Maximale Nachhaltigkeit bei maximaler Leistung.
Starten Sie Ihr Projekt mit uns
Kontaktieren Sie uns jetzt für Ihr individuelles Projekt!